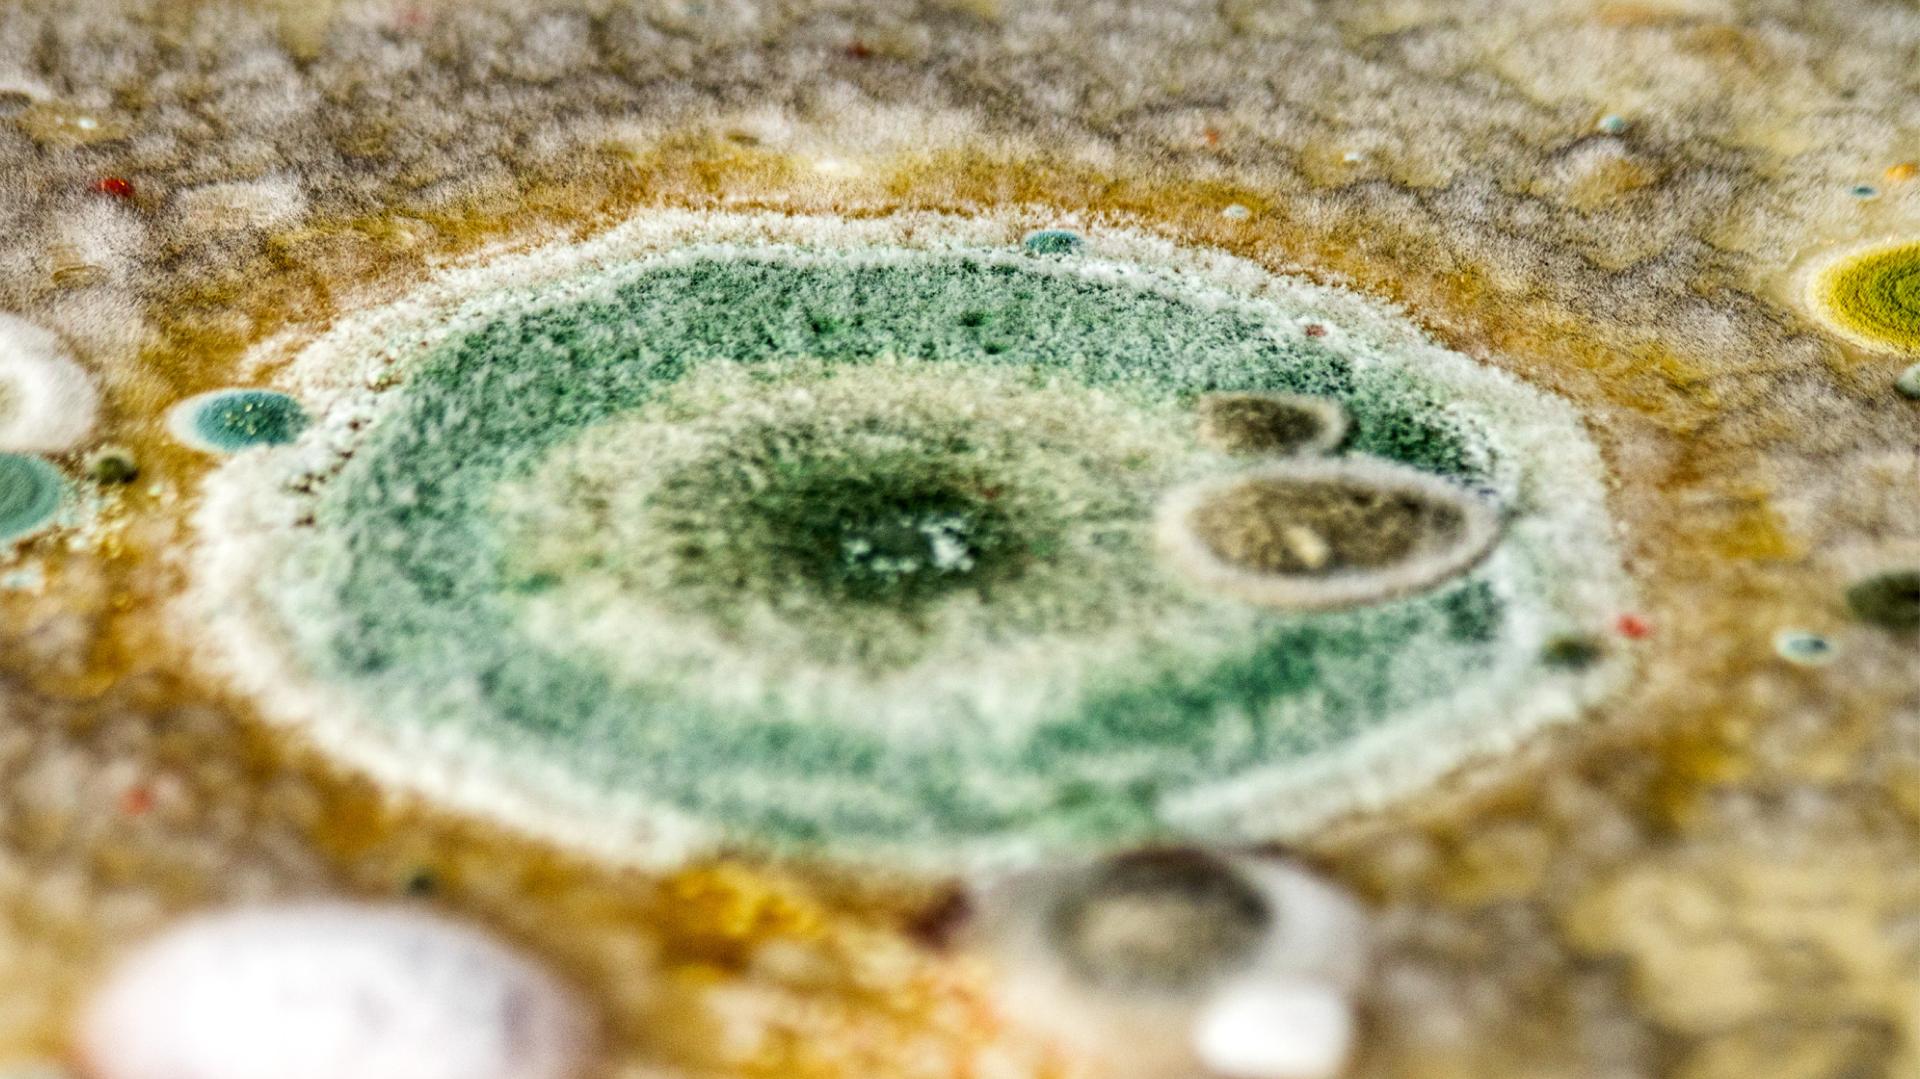
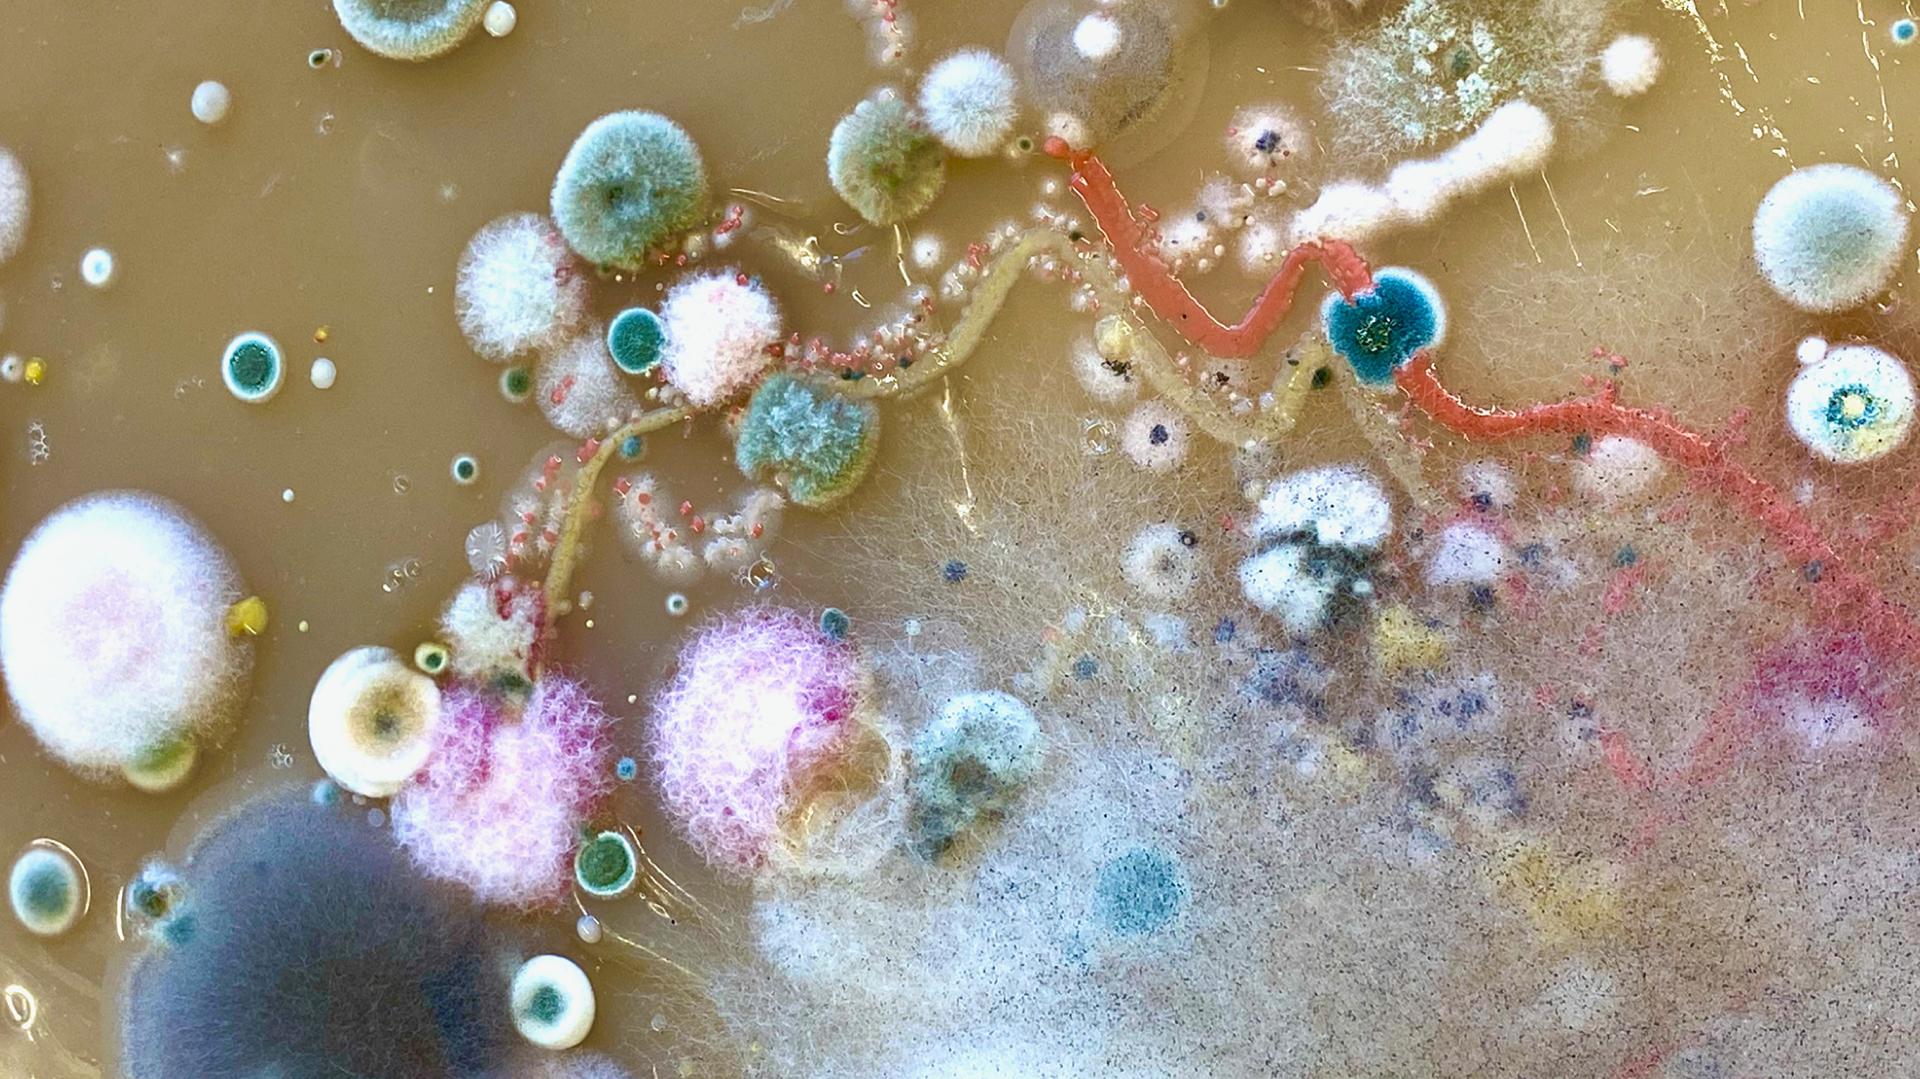

Planeta Kampus
Basic information
Project Title
Planeta Kampus
Full project title
Planeta Kampus
Category
Reconnecting with nature
Project Description
In the fictional spacetimes of Planeta Kampus, the natural phenomena are shifted. Plants are growing enormously; atmospheres are saturated with acid, and fungi decompose everything. How do we reconnect with these shifted environments? On Planeta Kampus, we are searching for creative forms of being in a state of climate change. The project uses imagination as a tool to explore the possibilities of our minds and the abilities of our bodies to live on a 'damaged planet.'
Geographical Scope
Local
Project Region
The campus of the University of West Bohemia in Pilsen, Czechia
Urban or rural issues
Mainly urban
Physical or other transformations
It refers to other types of transformations (soft investment)
EU Programme or fund
No
Description of the project
Summary
Planeta Kampus is an interdisciplinary project speculating about (im)possible ecosystem alterations in the era of the climate crisis and the consequences it has for the life of many more-than-human organisms. The fictional spacetimes of Planeta Kampus, where everything is uncertain, call us to adapt our knowledge, discourse, and bodies to these constantly shifting conditions. Our art-research group is searching for creative forms of being in the state of climate change.
Our research ground lies in the ecosystem of the University of West Bohemia campus, where we perform technological monitoring, scientific measurements, artistic investigations, conversations, and speculations of the current conditions. We are developing environmental monitoring stations, measuring the quality of air, water, and soil. We conduct collective observations, collecting samples and attuning to the complex natural networks forming on the campus. As artists and designers, we carry out DIY experiments, learning to work at the intersection of art and science.
The measured, collected, or created data from/in the existing ecosystem are the structural element for our science fiction speculations. We develop future extreme scenarios based on the data, forming the speculation ground for our environmental creation. So far, two Great Shifts have taken place on Planeta Kampus.
The first Great shift was the enormous growth. Trees thicken trunks, animals (dis) appear in intensive intervals, bacteria proliferate in the humus substrate, and mold decomposes everything. We needed to change our minds in this environment.
The second Great shift is extreme acidification. The levels of hazardous gases in the atmosphere became unbearable. In an environment with ph levels lower than 5, we need to change our bodies. With the teachings of many natural and artificial intelligences, we are learning ways how to grow an extensive layer of mucus on our skin and in our bodies, to be able to survive.
Our research ground lies in the ecosystem of the University of West Bohemia campus, where we perform technological monitoring, scientific measurements, artistic investigations, conversations, and speculations of the current conditions. We are developing environmental monitoring stations, measuring the quality of air, water, and soil. We conduct collective observations, collecting samples and attuning to the complex natural networks forming on the campus. As artists and designers, we carry out DIY experiments, learning to work at the intersection of art and science.
The measured, collected, or created data from/in the existing ecosystem are the structural element for our science fiction speculations. We develop future extreme scenarios based on the data, forming the speculation ground for our environmental creation. So far, two Great Shifts have taken place on Planeta Kampus.
The first Great shift was the enormous growth. Trees thicken trunks, animals (dis) appear in intensive intervals, bacteria proliferate in the humus substrate, and mold decomposes everything. We needed to change our minds in this environment.
The second Great shift is extreme acidification. The levels of hazardous gases in the atmosphere became unbearable. In an environment with ph levels lower than 5, we need to change our bodies. With the teachings of many natural and artificial intelligences, we are learning ways how to grow an extensive layer of mucus on our skin and in our bodies, to be able to survive.
Key objectives for sustainability
In the project of Planeta Kampus, our main aim is to address the need to abandon the anthropocentric discourse entangled in all parts of our western life. We believe in multispecies symbiosis being the primary step towards long-term sustainability. To understand the importance of the diversity of species, we need to notice their world-making capabilities.
In the first Great Shift happening on Planeta Kampus, we collaborated with mold to design 3-dimensional artifacts celebrating the possibilities of interspecies communication. Humans usually want to eliminate mold in their habitations, perceiving it as a hostile organism, without even realizing its importance in our micro and macro biomes. We provided habitat to the molds collected on the campus. Co-habiting an art studio with the many mold species made us think about the possibilities of co-creation with them. We developed technological tools for mold-human communication that deepen our relationships.
In the project, we are abandoning harmful production strategies by fabricating new biomaterials and acknowledging the workings of all human and non-human actors and natural phenomena participating in the production cycle - from fossils, water, bacteria, and animals to the weather and beyond.
We want to inspire people to notice their dependence on the more-than-human worlds and provide them with tools and materials to develop empathy and sympathy for our collaborators, helping us build a sustainable future.
We can only sustain, if we are able to adapt. Adaptation, multispecies collaboration, and imagination are the sustain-abilities we need to cultivate.
In the first Great Shift happening on Planeta Kampus, we collaborated with mold to design 3-dimensional artifacts celebrating the possibilities of interspecies communication. Humans usually want to eliminate mold in their habitations, perceiving it as a hostile organism, without even realizing its importance in our micro and macro biomes. We provided habitat to the molds collected on the campus. Co-habiting an art studio with the many mold species made us think about the possibilities of co-creation with them. We developed technological tools for mold-human communication that deepen our relationships.
In the project, we are abandoning harmful production strategies by fabricating new biomaterials and acknowledging the workings of all human and non-human actors and natural phenomena participating in the production cycle - from fossils, water, bacteria, and animals to the weather and beyond.
We want to inspire people to notice their dependence on the more-than-human worlds and provide them with tools and materials to develop empathy and sympathy for our collaborators, helping us build a sustainable future.
We can only sustain, if we are able to adapt. Adaptation, multispecies collaboration, and imagination are the sustain-abilities we need to cultivate.
Key objectives for aesthetics and quality
Changing climate scares us all, generating climate apathy that makes any collective action impossible. Planeta Kampus wants to propose new productive ways of relating to our ecosystems' destructive/constructive transformations.
Our art-research collective was born into the climate crisis. We never experienced a world without it. Our generation is also expected to do something about it. Furthermore, our generation is one of the first to live in the digital age of mainstream pop culture, social media, and memes. In the globalized world, pop culture is collectively consumed by most of the western world. Science fiction also plays an essential part in imagining our future. Memes, being funny, can communicate significant issues in today's world. It is funny because it is true. Can we use these for the most easily understood sources as tools for imagining the possible adaptations to climate change?
When the enormously toxic acid rains hit Planeta Kampus, we were looking for creative adaptations everywhere. Britney Spears singing in our minds: "Too much acid, can't come down, Losing coral, acid burning ground. Do you feel it now?" We remembered the mutations to mermaid bodies in H2O, Just Add Water. We were looking at commercials from Actimel, able to "strengthen our bodies." With these sources, we asked GPT-3 artificial intelligence for help. The solution for adapting our bodies to extremely acidified atmospheres turned out to be developing a thick layer of mucus. Humans usually want to eliminate mucus from their bodies without acknowledging its great importance for our bodies ability to live in toxic atmospheres.
In the project, we show the aesthetic qualities of species and materials usually considered disgusting. We aim to introduce them to pop culture, graphic design, and art - fields mainly responsible for constructing our taste. By doing this, we aim to transform our aesthetic preferences to see the transformations of our biomes from different perspective.
Our art-research collective was born into the climate crisis. We never experienced a world without it. Our generation is also expected to do something about it. Furthermore, our generation is one of the first to live in the digital age of mainstream pop culture, social media, and memes. In the globalized world, pop culture is collectively consumed by most of the western world. Science fiction also plays an essential part in imagining our future. Memes, being funny, can communicate significant issues in today's world. It is funny because it is true. Can we use these for the most easily understood sources as tools for imagining the possible adaptations to climate change?
When the enormously toxic acid rains hit Planeta Kampus, we were looking for creative adaptations everywhere. Britney Spears singing in our minds: "Too much acid, can't come down, Losing coral, acid burning ground. Do you feel it now?" We remembered the mutations to mermaid bodies in H2O, Just Add Water. We were looking at commercials from Actimel, able to "strengthen our bodies." With these sources, we asked GPT-3 artificial intelligence for help. The solution for adapting our bodies to extremely acidified atmospheres turned out to be developing a thick layer of mucus. Humans usually want to eliminate mucus from their bodies without acknowledging its great importance for our bodies ability to live in toxic atmospheres.
In the project, we show the aesthetic qualities of species and materials usually considered disgusting. We aim to introduce them to pop culture, graphic design, and art - fields mainly responsible for constructing our taste. By doing this, we aim to transform our aesthetic preferences to see the transformations of our biomes from different perspective.
Key objectives for inclusion
On Planeta Kampus, everyone, everything is already included. Planeta Kampus is all-inclusive. Inclusivity, especially that of non-humans, is the most crucial part of the project. (White male patriarchal) humans have declined agency to other humans and different animal species for too long. On Planeta Kampus, everyone already knows that the world is transformed by all of us. The first Great Shift proved it to us, for example, when the fungal colony destroyed the electrical transformer, the one making such horrible sounds on campus.
The inclusion of non-humans into the processes of designing is the essential principle in our environmental creation manifesto. In exhibitions and other forms of presentations, we always offer the possibility to infiltrate our artistic processes. Currently, our tools, codes, instructions, 3D models, pictures, and ideas are accessible through Google Drive, where we also encourage people to share their thoughts.
The Planeta Kampus project aims to develop open databases of all the collected and measured data that provide accessible and meaningful information for the students, tutors, and people of Pilsen. Currently, everyone can access some of the datasets through ThingSpeak. In the future, we plan to develop our own extensive archives of Planeta Kampus.
Education is an integral part of our project. Not only is Planeta Kampus located on the educational ground, but it also wants to be an educational platform with open databases, providing tutorials on multispecies interactions, environmental sensing, and workshops in imagining our future.
The inclusion of non-humans into the processes of designing is the essential principle in our environmental creation manifesto. In exhibitions and other forms of presentations, we always offer the possibility to infiltrate our artistic processes. Currently, our tools, codes, instructions, 3D models, pictures, and ideas are accessible through Google Drive, where we also encourage people to share their thoughts.
The Planeta Kampus project aims to develop open databases of all the collected and measured data that provide accessible and meaningful information for the students, tutors, and people of Pilsen. Currently, everyone can access some of the datasets through ThingSpeak. In the future, we plan to develop our own extensive archives of Planeta Kampus.
Education is an integral part of our project. Not only is Planeta Kampus located on the educational ground, but it also wants to be an educational platform with open databases, providing tutorials on multispecies interactions, environmental sensing, and workshops in imagining our future.
How Citizens benefit
Even though being a fictional space, Planeta Kampus is situated on the University of West Bohemia campus, where all our activities occur. The motivation for the project was to bring a different perspective on the campus space, its qualities, inhabitants, and their temporalities. Thousands of students pass by daily to gain new knowledge, knowing nothing about the processes of the environment itself. One of our goals is to build another level of educational infrastructure full of knowledge about the academic ground itself.
Citizens of Planeta Kampus can benefit from the open databases about the ecosystem's water, soils, and air. To engage all the campus inhabitants, we plan to organize observation tours and imagination workshops to attune and think-with the campus about our possible adaptations. Through these small steps, we want to engage the campus leadership and take meaningful actions toward a sustainable campus full of meaningful multispecies interactions.
Citizens of Planeta Kampus can benefit from the open databases about the ecosystem's water, soils, and air. To engage all the campus inhabitants, we plan to organize observation tours and imagination workshops to attune and think-with the campus about our possible adaptations. Through these small steps, we want to engage the campus leadership and take meaningful actions toward a sustainable campus full of meaningful multispecies interactions.
Physical or other transformations
It refers to other types of transformations (soft investment)
Innovative character
The diversity of our artistic-research group made the project involve many different fields, conceptualized from many different perspectives, leading to a manifold of outcomes. Planeta Kampus grows underground, where the most significant transformations occur, like a mycelial network in all directions, searching for nutritious soils they can absorb and once in a while produce fruiting bodies. The innovative character of Planeta Kampus lies precisely in this art to connect - humans and non-humans, science and art, art and architecture, technology and nature - and to produce at the intersections of these connections.
Inspired by the open-source DIY culture of amateur mycologists, and scientists, we adapt their curiosity and methods to explore the boundaries of artistic-scientific-social intersections.
Our findings, measurements, ideas, and speculations are communicated through texts (fictional stories, diaries, dreams), symbolical visual artifacts (3D printed objects, 2D symbols, non-anthropogenic fonts, generative graphics, AI visions), virtual worlds (digital interactive environments), sounds (field-recordings, generative sounds, AI written songs), data visualizations of environmental data, graphically illustrated instructions, codes, designs, and many more.
The innovative character of Planeta Kampus is its ability to assimilate all kinds of fields - from art through philosophy and technology to all areas of science.
Inspired by the open-source DIY culture of amateur mycologists, and scientists, we adapt their curiosity and methods to explore the boundaries of artistic-scientific-social intersections.
Our findings, measurements, ideas, and speculations are communicated through texts (fictional stories, diaries, dreams), symbolical visual artifacts (3D printed objects, 2D symbols, non-anthropogenic fonts, generative graphics, AI visions), virtual worlds (digital interactive environments), sounds (field-recordings, generative sounds, AI written songs), data visualizations of environmental data, graphically illustrated instructions, codes, designs, and many more.
The innovative character of Planeta Kampus is its ability to assimilate all kinds of fields - from art through philosophy and technology to all areas of science.
Disciplines/knowledge reflected
On the most theoretical level, it builds on the writings of posthumanist and new materialist scholars, emphasizing the need to entangle the anthropocentrically divided concepts of nature and culture. Environmental philosophy is another important field that dramatically impacts how we view and describe our findings. Our solid theoretical focus on ethics in the more-than-human world helped us to establish meaningful interactions with fungal and bacterial worlds.
We learn a lot about and from molds by being close to molds. We became aware of its health risks on the human respiratory system and realized the boundaries that must be kept in mind. We started to cultivate molds from a pure curiosity of environmental design students. Our DIY artistic approach to science helped us come up with unusual procedures. During the process, we researched a lot about the different species of mold, their behavior, growth, reproduction, and cultivation.
Planeta Kampus emerged as an architectural project researching and intervening in the spatial and infrastructural dimensions of the university campus. We focus on multi-centered architecture and designing products for/with non-humans that can be embedded in the campus environment. In collaboration with the Faculty of Applied Sciences, we develop environmental monitoring infrastructures across campus.
The fictional spacetimes of Planeta Kampus are presented in texts and a virtual game-like environment, a digital twin of the campus, where we can simulate different climate conditions. People are invited to interact with this environment in virtual reality, being guided by sounds and visuals. The virtual environments are, on the one side, laboratories, where we can model and simulate the happenings on Planeta Kampus, and on the other side, experiences, and invitations for humans to reconnect with these shifted conditions.
We invite artificial intelligence to our process to help us find ways to adapt to climate change.
We learn a lot about and from molds by being close to molds. We became aware of its health risks on the human respiratory system and realized the boundaries that must be kept in mind. We started to cultivate molds from a pure curiosity of environmental design students. Our DIY artistic approach to science helped us come up with unusual procedures. During the process, we researched a lot about the different species of mold, their behavior, growth, reproduction, and cultivation.
Planeta Kampus emerged as an architectural project researching and intervening in the spatial and infrastructural dimensions of the university campus. We focus on multi-centered architecture and designing products for/with non-humans that can be embedded in the campus environment. In collaboration with the Faculty of Applied Sciences, we develop environmental monitoring infrastructures across campus.
The fictional spacetimes of Planeta Kampus are presented in texts and a virtual game-like environment, a digital twin of the campus, where we can simulate different climate conditions. People are invited to interact with this environment in virtual reality, being guided by sounds and visuals. The virtual environments are, on the one side, laboratories, where we can model and simulate the happenings on Planeta Kampus, and on the other side, experiences, and invitations for humans to reconnect with these shifted conditions.
We invite artificial intelligence to our process to help us find ways to adapt to climate change.
How stakeholders are engaged
The project of Planeta Kampus emerged from the initiative of the campus leadership to transform the campus into a more pleasant environment for humans. Together with architect Zdeněk Fránek, University of West Bohemia leadership, and our other classmates, we discussed the architecture and infrastructure of the campus, searching for possible ecological transformations, with many architectural designs emerging from the conversations. Planeta Kampus emerged from the need for a more-than-human perspective in the development plans.
Professor Zdeněk Fránek, as a supervisor of the project, connected us to meaningful collaborators, consultants, and resource providers.
The city of Pilsen got involved in the project by providing us with valuable resources and consulting with us on the possibilities of development on the urban level.
One of the most naturally diverse places on campus is a small wild forest manifold of massive pines, fragile birches, colorful pheasants, and mycelial networks. This lively ecosystem should have been cut down to create a small water reserve where humans can enjoy sunny days. Destroying one functional ecosystem to develop another made us think about human activities' implications on nature. Planeta Kampus, from the beginning, was meant to serve as a direct message to these harmful human interests forgetting about the more-than-human world. Planeta Kampus aims to bring the perspective of all of its inhabitants to the campus developments. The educational grounds of the University of West Bohemia campus became the material source of meaningful knowledge.
Professor Zdeněk Fránek, as a supervisor of the project, connected us to meaningful collaborators, consultants, and resource providers.
The city of Pilsen got involved in the project by providing us with valuable resources and consulting with us on the possibilities of development on the urban level.
One of the most naturally diverse places on campus is a small wild forest manifold of massive pines, fragile birches, colorful pheasants, and mycelial networks. This lively ecosystem should have been cut down to create a small water reserve where humans can enjoy sunny days. Destroying one functional ecosystem to develop another made us think about human activities' implications on nature. Planeta Kampus, from the beginning, was meant to serve as a direct message to these harmful human interests forgetting about the more-than-human world. Planeta Kampus aims to bring the perspective of all of its inhabitants to the campus developments. The educational grounds of the University of West Bohemia campus became the material source of meaningful knowledge.
Global challenges
Planeta Kampus addresses the vastest global challenge we - all beings entangled on this planet, face - climate change. Overcoming challenges is in human nature - with this mindset, we developed one for which we may be too small. Planeta Kampus is not about fighting against climate, humans versus nature, because, let’s face it, we can never win this battle. Therefore, the actual global challenge we address in our project is the challenge of the human ego and human subjectivity.
On Planeta Kampus, we are exploring ways to vibrate at the same frequency as our surroundings and neighbors. Adaptation is the basis of a joyful being. We don’t know what the future climate holds. But Planeta Kampus aims to be our testing ground, where every scenario is possible, where we can imagine unimaginable extremes and constantly learn to adapt to them. We want to acquire the intelligence of chameleons, chimeras, bacteria, fungi, grass, artificial intelligence, and every other species, who are probably better prepared for what we face with their adaptive qualities.
In a hurry to overcome nature, humans have developed the most monumental development project - climate change. Planeta Kampus is situated in this state of our world as a place to change our mindsets. When facing extreme conditions, the human ego goes aside; teamwork begins, and a different perspective is taken.
On Planeta Kampus, we are exploring ways to vibrate at the same frequency as our surroundings and neighbors. Adaptation is the basis of a joyful being. We don’t know what the future climate holds. But Planeta Kampus aims to be our testing ground, where every scenario is possible, where we can imagine unimaginable extremes and constantly learn to adapt to them. We want to acquire the intelligence of chameleons, chimeras, bacteria, fungi, grass, artificial intelligence, and every other species, who are probably better prepared for what we face with their adaptive qualities.
In a hurry to overcome nature, humans have developed the most monumental development project - climate change. Planeta Kampus is situated in this state of our world as a place to change our mindsets. When facing extreme conditions, the human ego goes aside; teamwork begins, and a different perspective is taken.
Learning transferred to other parties
From the beginning of the Planeta Kampus project, we aim to develop a manifesto for environmental creation and design that has the potential to serve as an inspiration for creative people to invite non-human beings into their art/design process, to become aware of the more-than-human world's massive impact on their current practice, to reflect on their aesthetic preferences and the way it structures their practice, to use imagination as a tool to design for (im)possible spacetimes of the climate crisis.
The webs of Planeta Kampus want to grow beyond its borders. The openly accessible methods, practices, and codes invite other creatives to use them in different contexts and let the spores spread!
The webs of Planeta Kampus want to grow beyond its borders. The openly accessible methods, practices, and codes invite other creatives to use them in different contexts and let the spores spread!
Keywords
imagination
speculative design
collaboration
non-human intelligence
interdisciplinarity